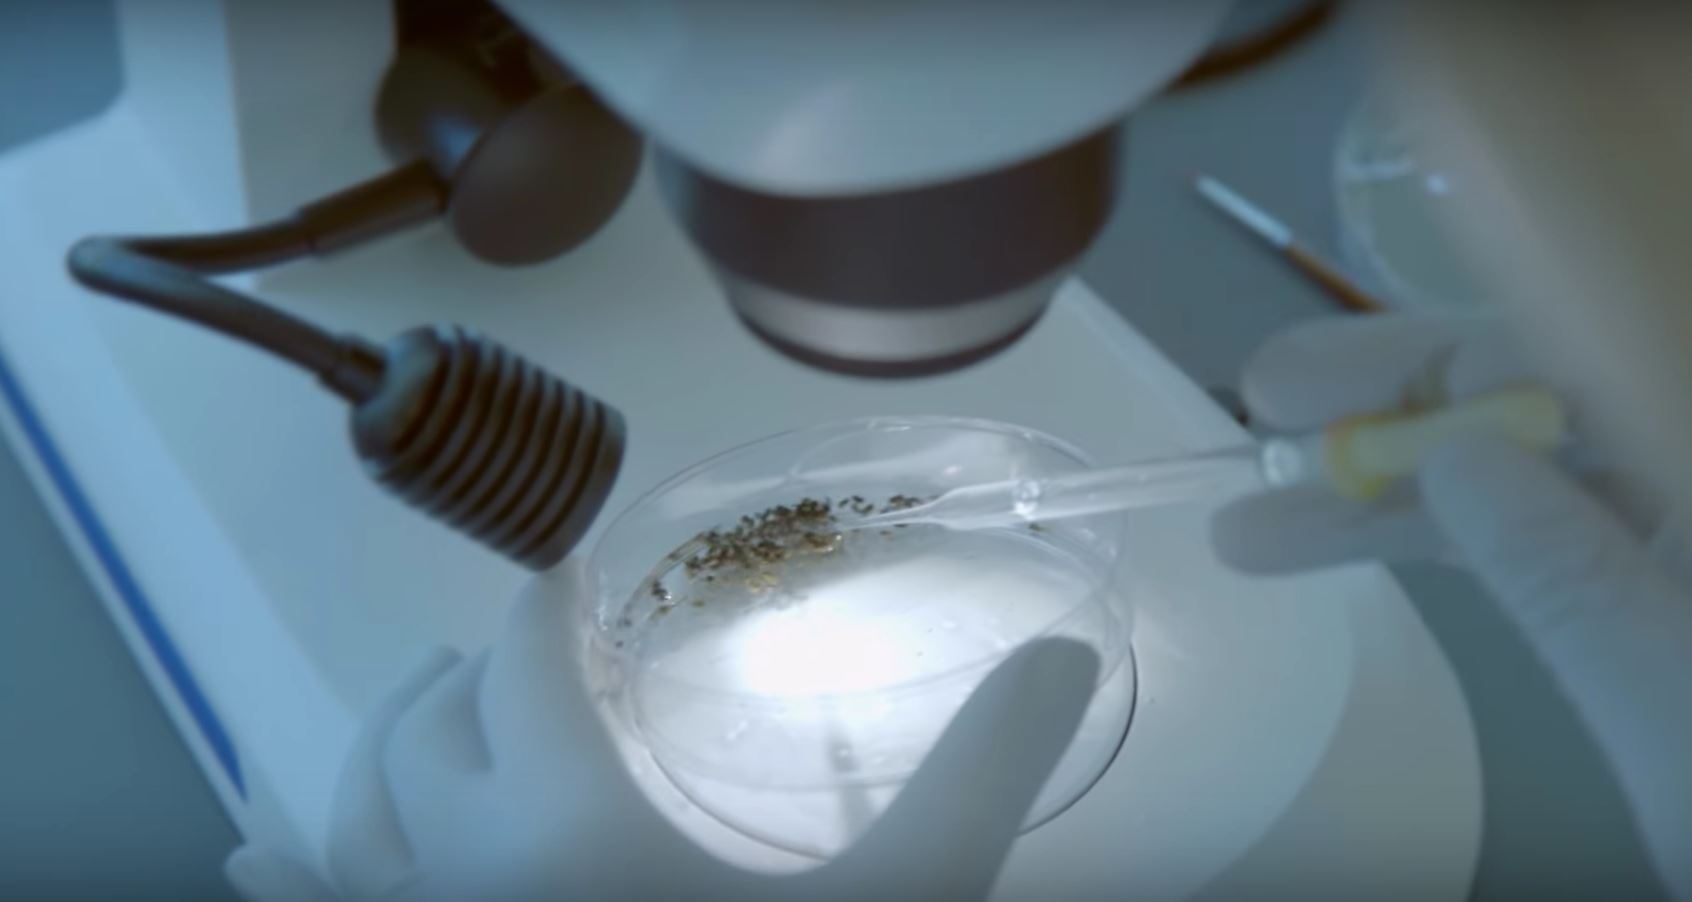
control mosquitos verily google insects1

Puede parecer contradictorio, pero para combatir el Zika y otras enfermedades transmitidas por mosquitos, un equipo de científicos de la Unidad de Ciencias Biológicas Verily de Google está liberando alrededor de 20 millones de esos insectos en Fresno, California.
Esta decisión forma parte de Project Debug de Verily, una iniciativa internacional anunciada el año pasado con la misión de reducir «el devastador impacto en la salud global que los mosquitos portadores de enfermedades infligen a la gente de todo el mundo». Y ahora, la compañía está lanzando el proyecto Debug Fresno en los Estados Unidos, que pondrá a prueba un método de control de mosquitos que implica la técnica de insectos estériles.
En esencia, los 20 millones de mosquitos que Verily está liberando son todos machos estériles que han sido tratados con Wolbachia, una bacteria de origen natural. Durante las próximas 20 semanas, estos insectos serán lanzados en dos vecindarios de alrededor de 300 acres. La esperanza es que, si estos machos estériles se aparean con las hembras silvestres, que pueden transportar y transmitir una serie de enfermedades incluyendo Zika, dengue y chikungunya, los huevos resultantes no eclosionen.
Verily determinará el éxito de su prueba comparando la densidad adulta de la población de esta clase particular de mosquito, y la cantidad de huevos que no resultaron en nuevos mosquitos, en los vecindarios en los que se realizó la prueba versus los que no fueron tratados.
Linus Upson, uno de los ingenieros de Verily, dijo a MIT Technology Review que esto podría convertirse en una forma económica y efectiva de controlar las poblaciones de mosquitos y reducir o eliminar enfermedades, aunque no dijo cuánto cuesta exactamente este experimento. «Si realmente queremos ser capaces de ayudar a la gente en todo el mundo, tenemos que ser capaces de producir muchos mosquitos, distribuirlos a donde deben estar y medir las poblaciones a costos muy bajos», dijo. «Queremos mostrar que esto puede funcionar en diferentes tipos de ambientes».
Alphabet, la compañía de Google, cambió de nombre a su equipo de Ciencias Biológicas de Google y lo llamó Verily a finales de 2015, afirmando que el equipo se alejaría de Google y se convertiría en una propia división independiente.
Se dice que la prueba a llevarse a cabo en Fresno es la liberación más grande de mosquitos masculinos estériles en los Estados Unidos hasta el momento. Si vives en el área y te preocupa que esos 20 millones de mosquitos sean una peste difícil de controlar en cuanto a picaduras, recuerda que los mosquitos machos no pican. Así que, aunque seguramente verás más de esas criaturas en las próximas semanas, ten la seguridad que todo es por buen propósito.